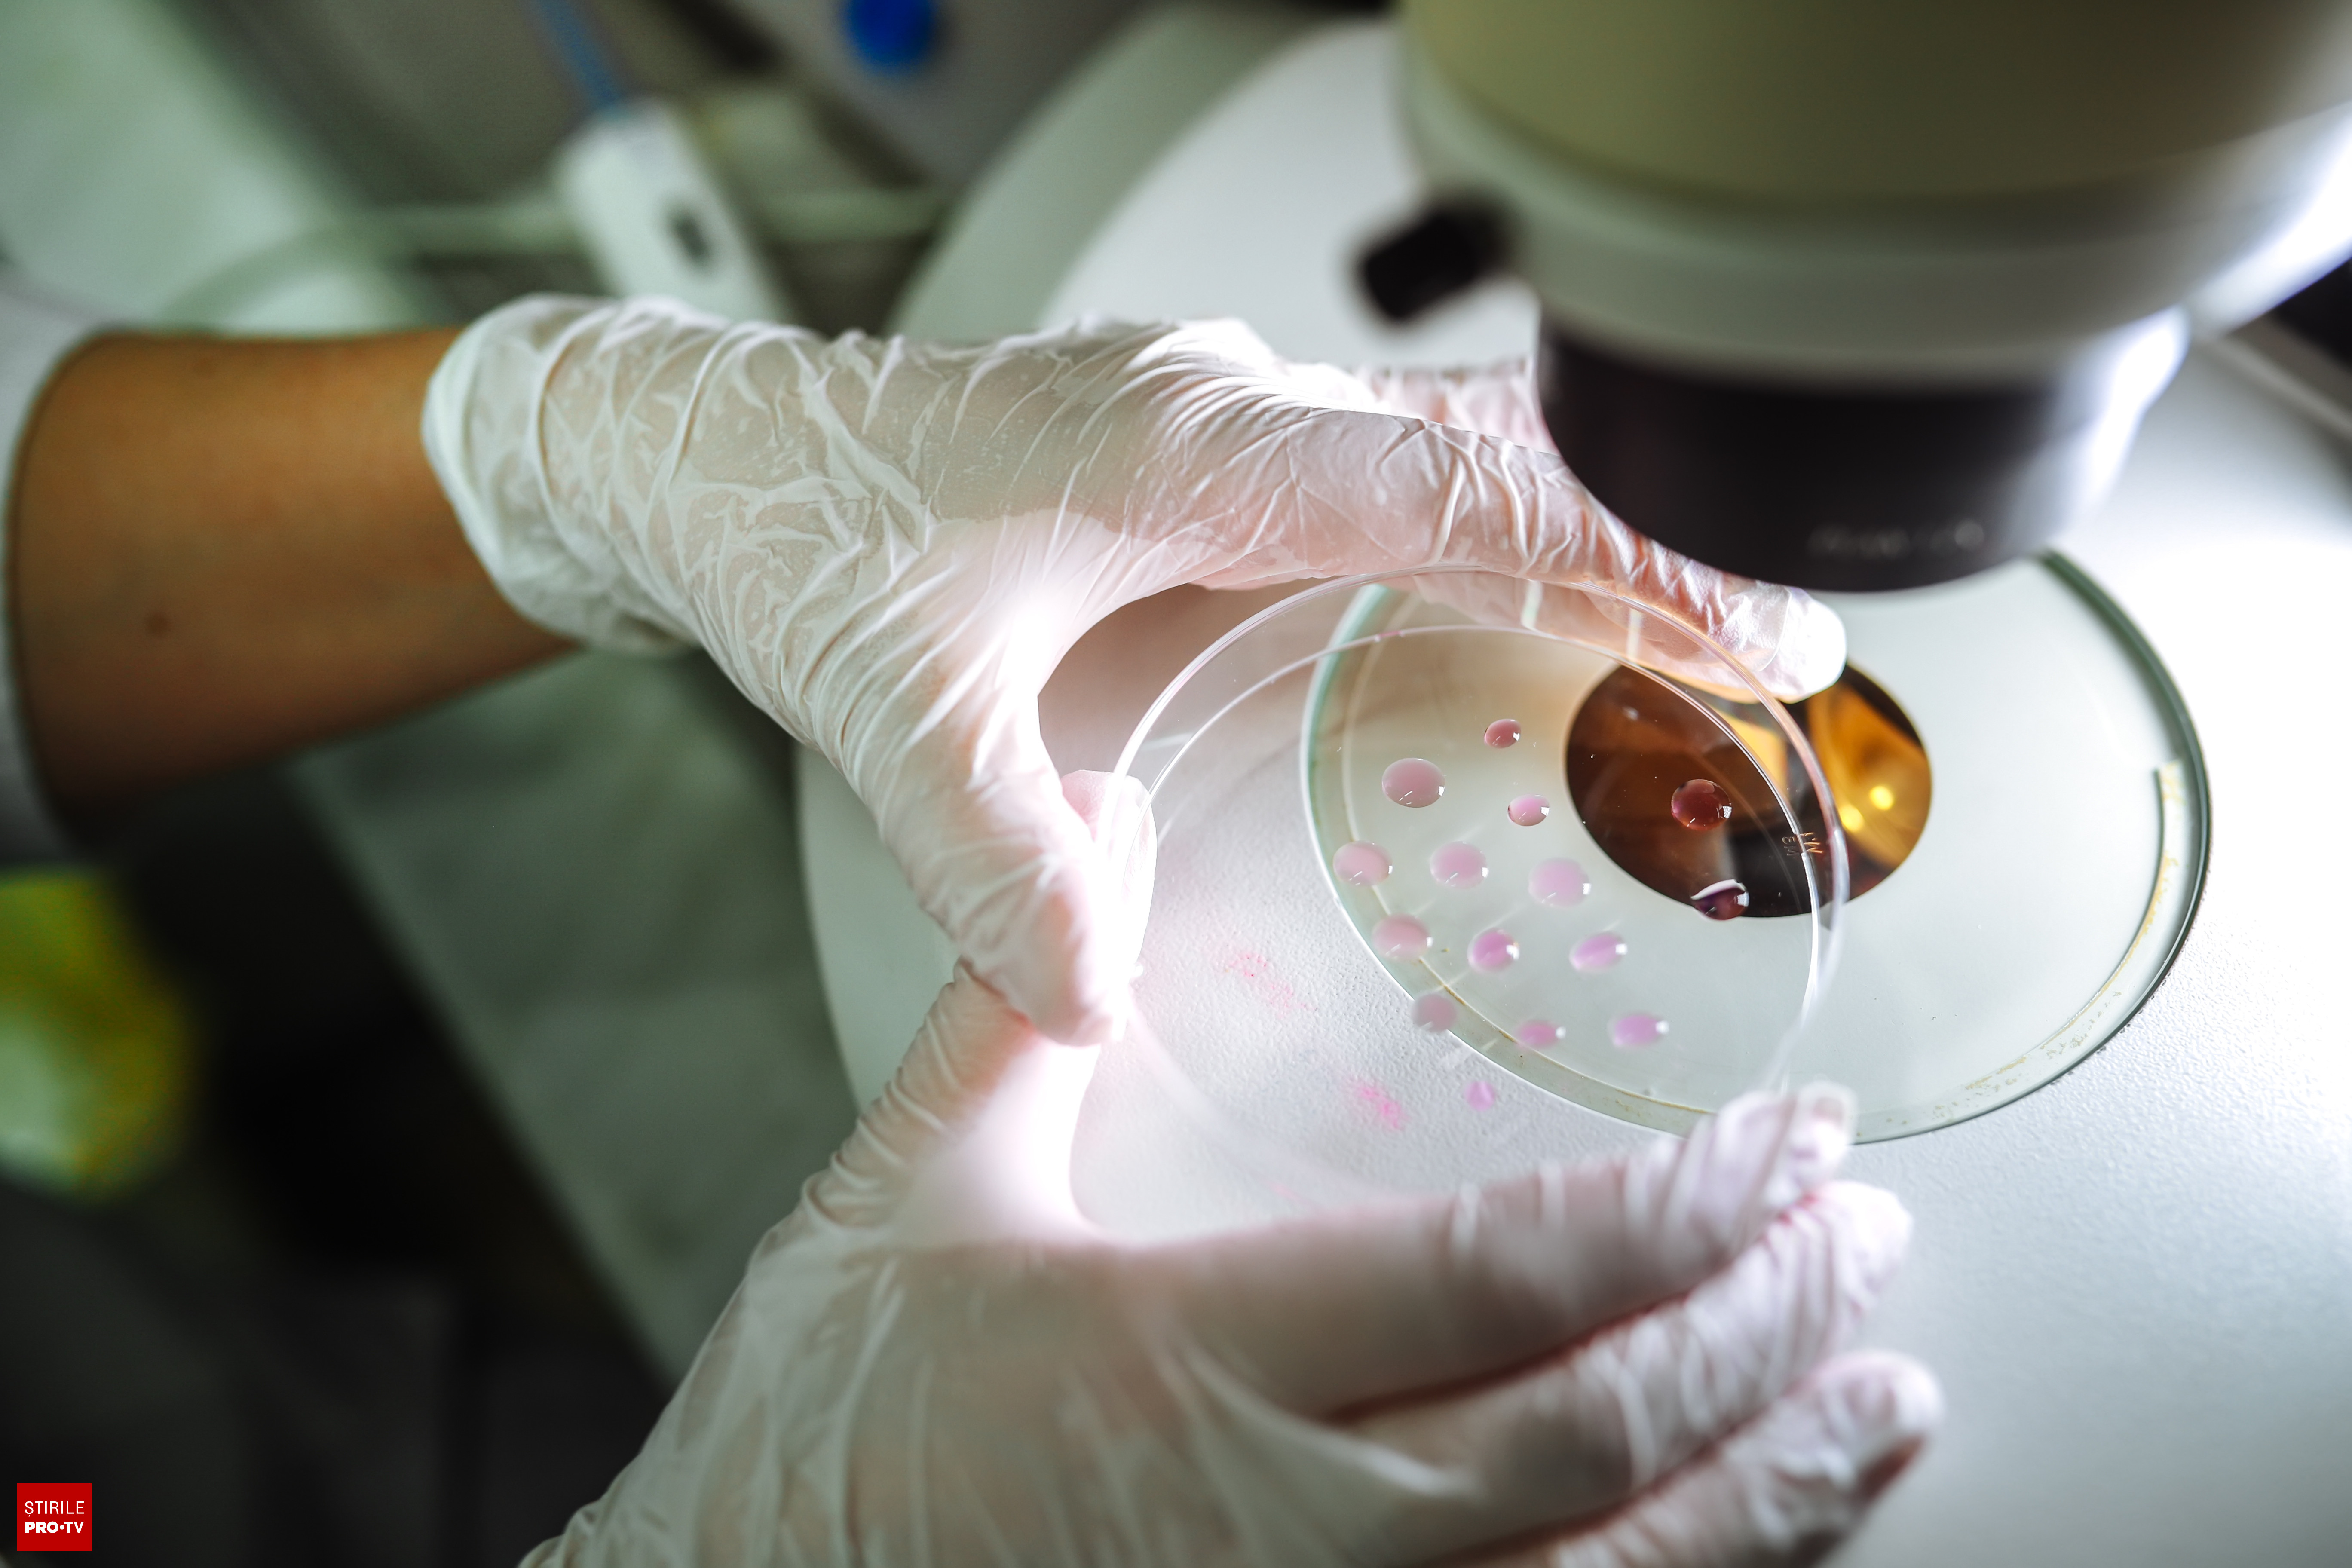

În noaptea dintre 1 și 2 aprilie, persoane necunoscute au incendiat o casă din lemn de pe un teren extravilan în comuna Cetate, aparținând poetului Mircea Dinescu. Incendiul a distrus proprietatea, iar prejudiciul estimat se ridică la aproximativ 100.000 de euro.
Polițiștii din Secția 9 Rurală Cetate au deschis dosar penal pentru distrugere prin incendiere și au început cercetările pentru identificarea făptașilor. Mircea Dinescu a depus și el plângere oficială la Parchet.
Investigațiile sunt în curs, urmând ca la finalizarea lor să se dispună măsurile legale corespunzătoare. Incidentul a atras atenția asupra protecției proprietăților personale și a celor culturale.
Motivul selecției: Incendierea casei unui personaj public marchează un incident grav de distrugere cu implicații legale și sociale, generând interes pentru anchetă și securitate.
Pagina dedicată pentru Casa poetului Mircea Dinescu din Dolj, incendiată cu prejudiciu estimat de 100.000 euro